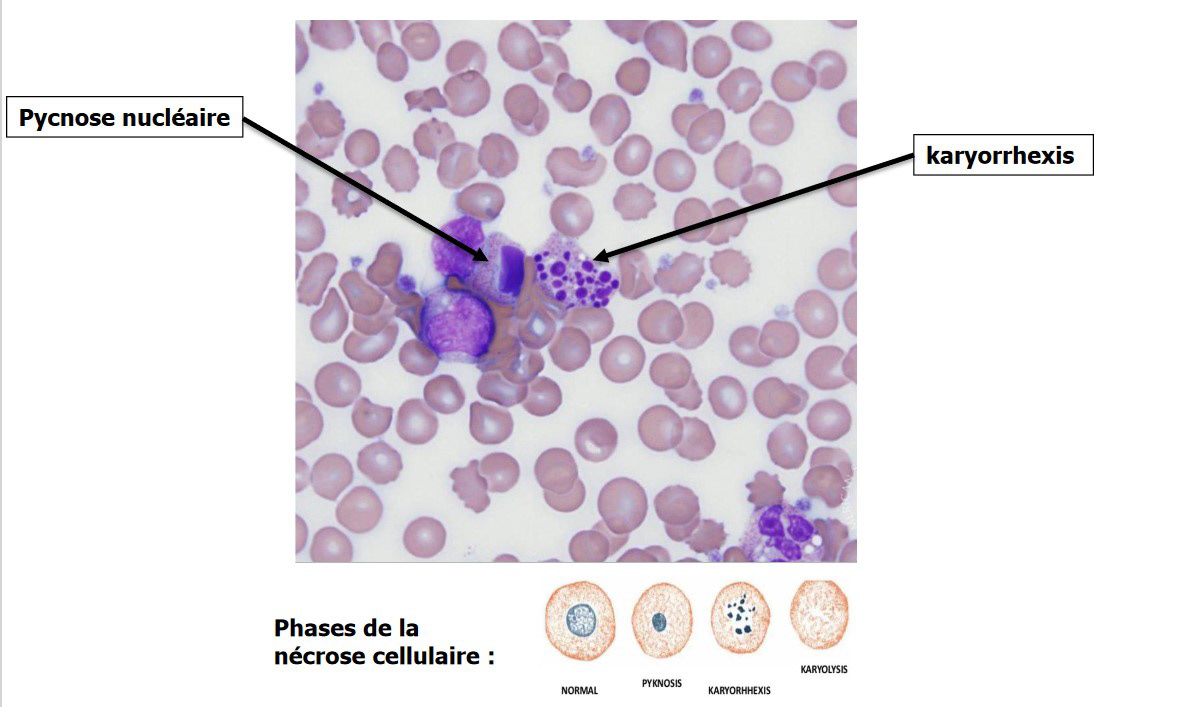

Created for H&O Equipments, this educational video is based on scientific sources to make complex medical mechanisms accessible.
It explains infection and wart propagation processes, presents cryosurgery treatment, and illustrates the stages of skin cell regeneration.
It explains infection and wart propagation processes, presents cryosurgery treatment, and illustrates the stages of skin cell regeneration.
The full project development — from research to final delivery — took four months.
Scientific documentation, storyboard, data management, 3D modelling, animation, editing, sound design, validation phases and final publication.